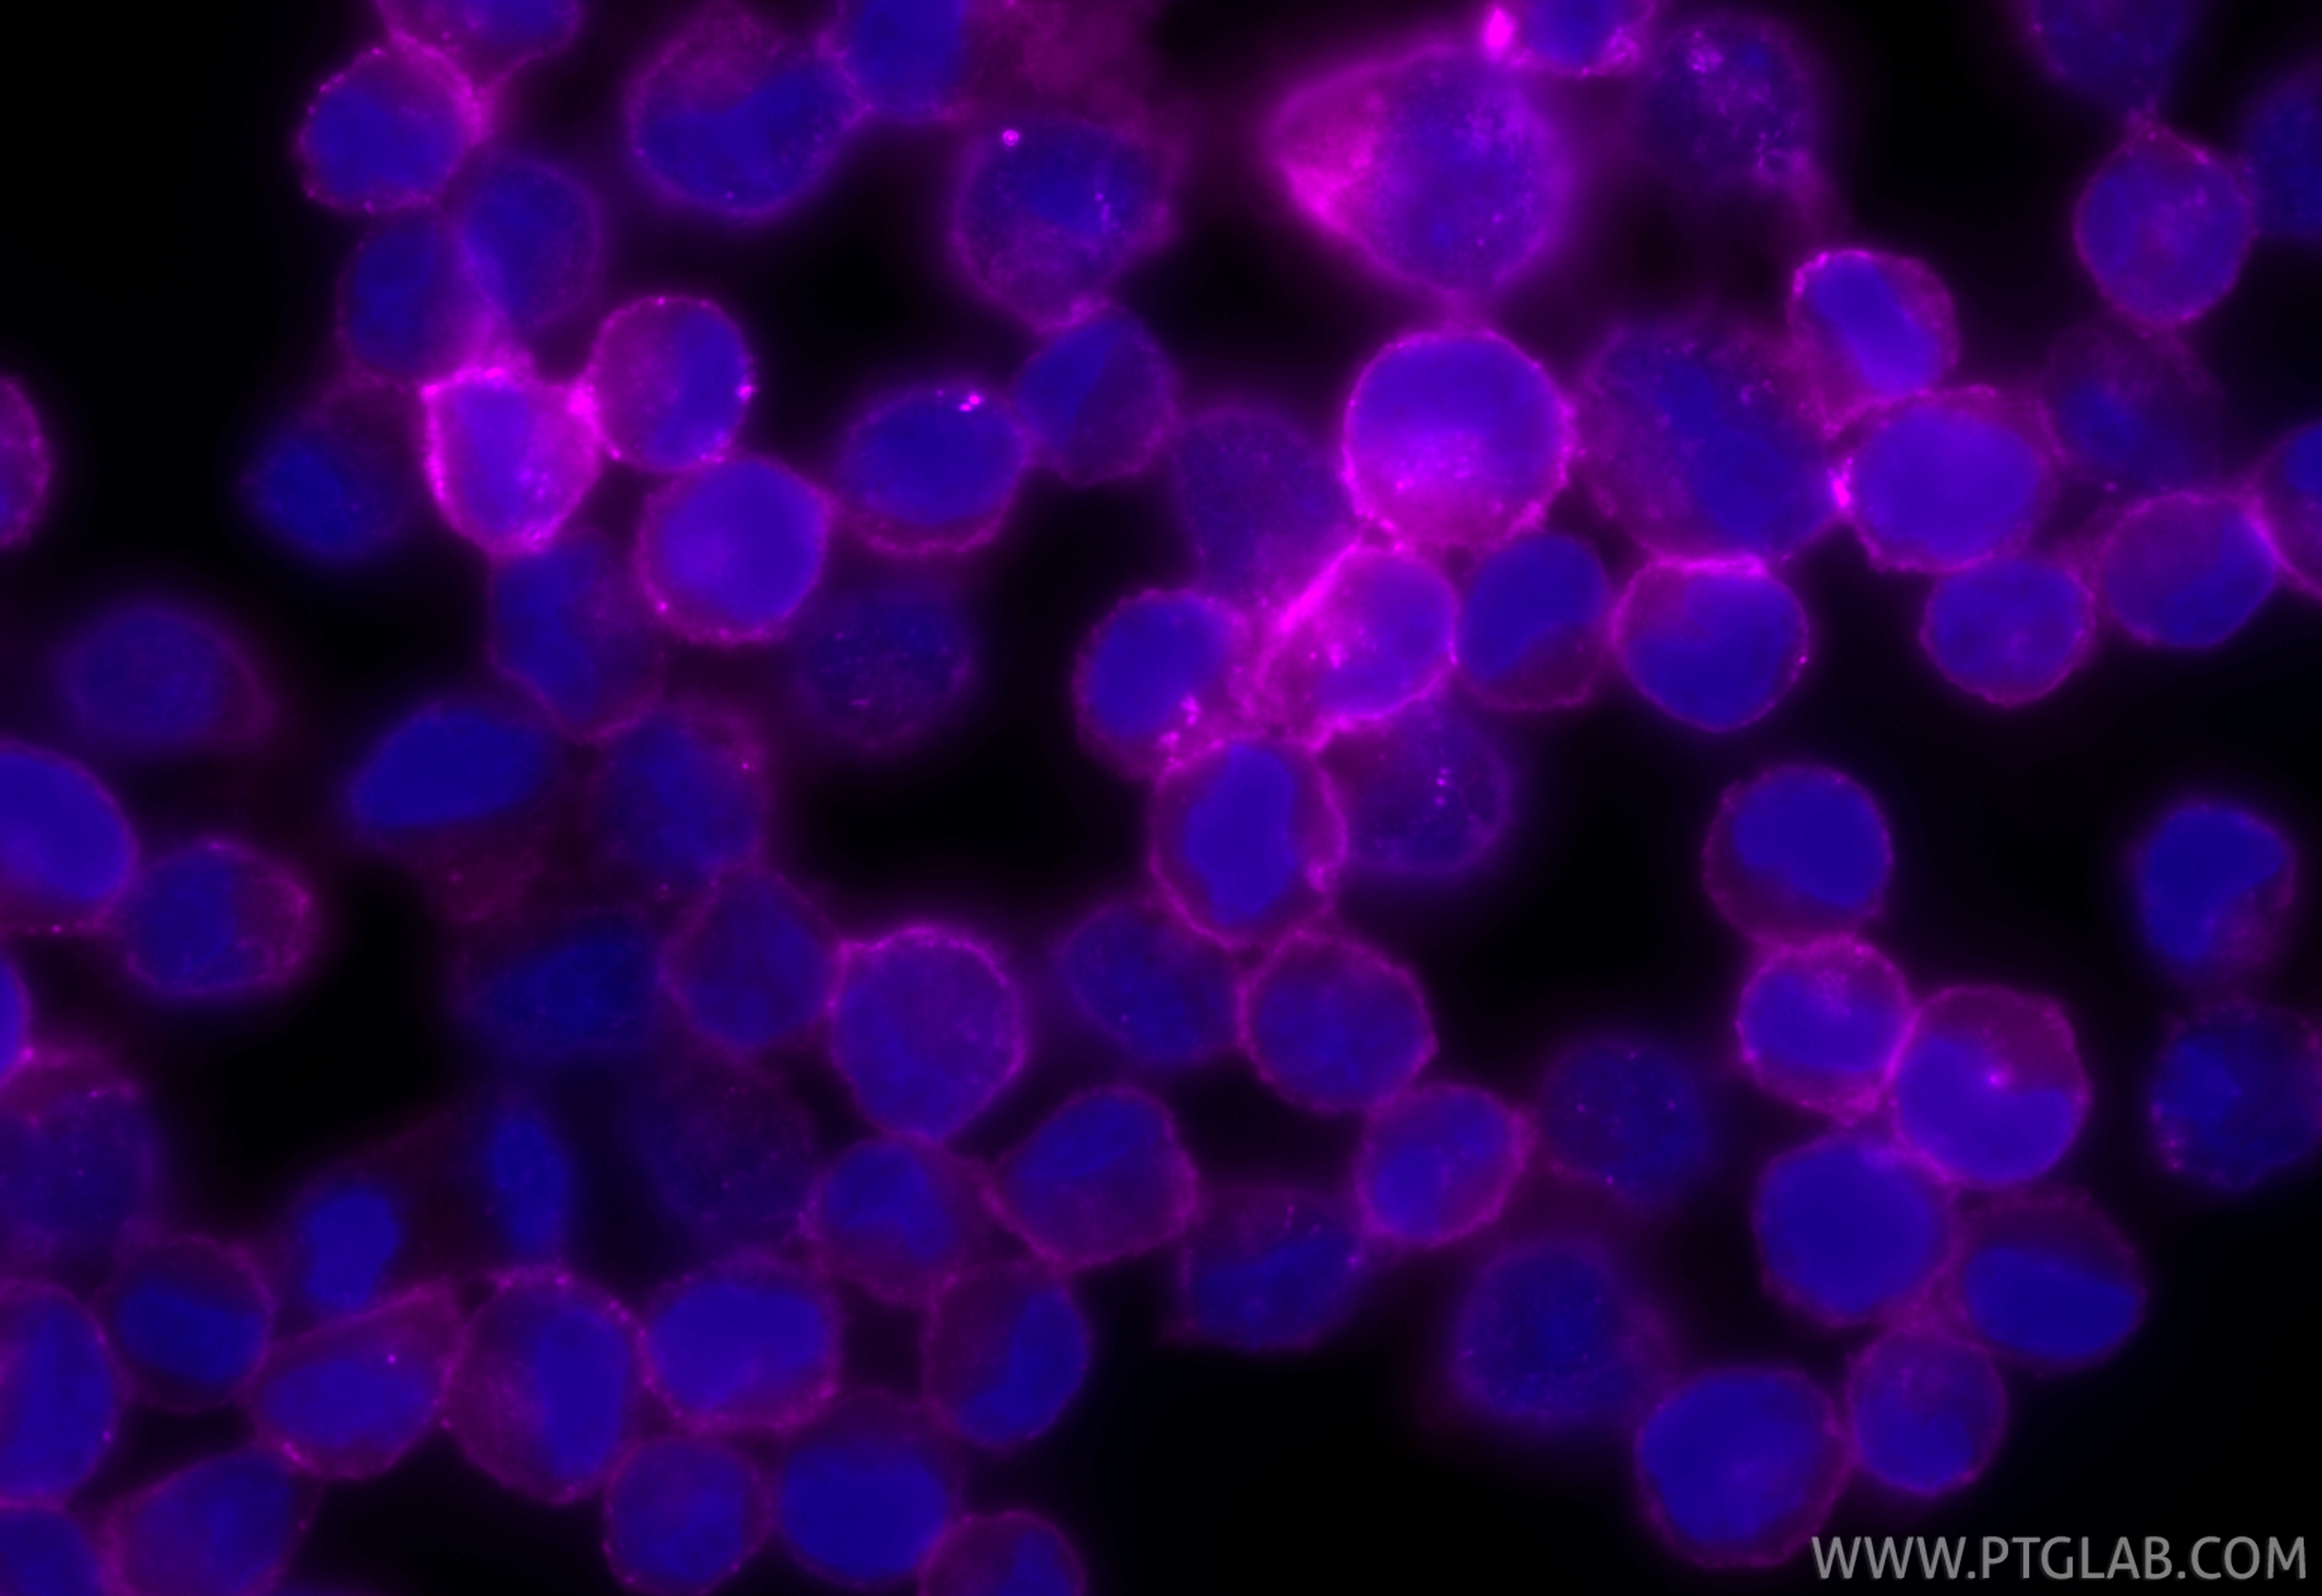
Immunofluorescence (IF) / fluorescent staining of K-562 cells using CoraLite® Plus 647-conjugated Nectin-2/CD112 Recom (CL647-84460-5)

Tested Applications
| Positive IF/ICC detected in | K-562 cells |
Recommended dilution
| Application | Dilution |
|---|---|
| Immunofluorescence (IF)/ICC | IF/ICC : 1:50-1:500 |
| It is recommended that this reagent should be titrated in each testing system to obtain optimal results. | |
| Sample-dependent, Check data in validation data gallery. | |
Product Information
CL647-84460-5 targets Nectin-2/CD112 in IF/ICC applications and shows reactivity with human samples.
| Tested Reactivity | human |
| Host / Isotype | Rabbit / IgG |
| Class | Recombinant |
| Type | Antibody |
| Immunogen |
CatNo: Eg1670 Product name: Recombinant Human Nectin-2/CD112 protein (rFc Tag) Source: mammalian cells-derived, pHZ-KIsec-C-rFc Tag: C-rFc Domain: 32-360 aa of NM_001042724.2 Sequence: QDVRVQVLPEVRGQLGGTVELPCHLLPPVPGLYISLVTWQRPDAPANHQNVAAFHPKMGPSFPSPKPGSERLSFVSAKQSTGQDTEAELQDATLALHGLTVEDEGNYTCEFATFPKGSVRGMTWLRVIAKPKNQAEAQKVTFSQDPTTVALCISKEGRPPARISWLSSLDWEAKETQVSGTLAGTVTVTSRFTLVPSGRADGVTVTCKVEHESFEEPALIPVTLSVRYPPEVSISGYDDNWYLGRTDATLSCDVRSNPEPTGYDWSTTSGTFPTSAVAQGSQLVIHAVDSLFNTTFVCTVTNAVGMGRAEQVIFVRETPRASPRDVGPL Predict reactive species |
| Full Name | poliovirus receptor-related 2 (herpesvirus entry mediator B) |
| Calculated Molecular Weight | 58 kDa |
| GenBank Accession Number | NM_001042724.2 |
| Gene Symbol | Nectin-2/CD112 |
| Gene ID (NCBI) | 5819 |
| Conjugate | CoraLite® Plus 647 Fluorescent Dye |
| Excitation/Emission Maxima Wavelengths | 654 nm / 674 nm |
| Form | Liquid |
| Purification Method | Protein A purification |
| UNIPROT ID | Q92692-2 |
| Storage Buffer | PBS with 50% glycerol, 0.05% Proclin300, 0.5% BSA, pH 7.3. |
| Storage Conditions | Store at -20°C. Avoid exposure to light. Stable for one year after shipment. Aliquoting is unnecessary for -20oC storage. |
Background Information
Nectin 2, also named as PVRL2, CD112, HVEB, PRR2 and PVRR2, is an adhesion molecule widely expressed in cell lines of different lineages, including hematopoietic, neuronal, endothelial and epithelial cells. CD112 belongs to a new family of immunoglobulin-like molecules that includes four members (CD111, CD112, PRR3 and CD155) sharing an ectodomain made of three Ig domains, of V and C types. CD112 is expressed in the myelo-monocytic and megakaryocytic hematopoietic lineages and the function in hematopoiesis is currently unknown. CD112 is an intercellular homophilic adhesion. CD112 localizes specifically at adherents junctions via its cytoplasmic interaction with the scaffold F-actin binding protein afadin. Disruption of the murine CD112 gene leads to infertility of male mice with morphologically aberrant spermatozoa. CD112 mediates entry of some alphaherpesvirus mutants (also named HveB) via its V domain. CD112 is involved in cell to cell spreading of viruses.
Protocols
| Product Specific Protocols | |
|---|---|
| IF protocol for CL Plus 647 Nectin-2/CD112 antibody CL647-84460-5 | Download protocol |
| Standard Protocols | |
|---|---|
| Click here to view our Standard Protocols |